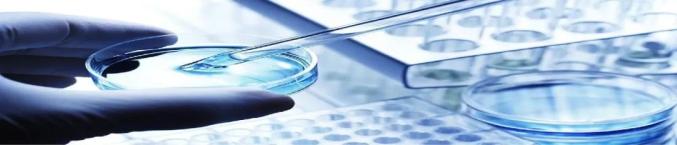

- +1
中国侨商投资(河南)大会系列宣传——南阳
南阳古称“宛”,位于河南省西南部、豫鄂陕三省交界处,总面积2.66万平方公里,常住人口971万,2022年,全市实现生产总值4555亿元,是河南省面积最大、户籍人口最多、经济总量第三的省辖市,是河南省委、省政府明确支持建设的现代化省域副中心城市,是国家历史文化名城、全国文明城市、国家卫生城市、国家森林城市。
南阳是一座底蕴深厚的历史文化名城。有5000年文明史,2700多年建城史,楚汉文化发祥于此,光武帝刘秀起兵于南阳,有“南都”“帝乡”之称。历史上,曾哺育出商圣范蠡、科圣张衡、医圣圣张仲景、智圣诸葛亮“四圣”先贤。近现代,南阳院士群体、教育家群体、法学家群体、作家群体蜚声全国。南阳籍“两院”院士约占河南籍院士总数的1/3,有“河南院士之乡”的美誉。
南阳是一座山清水秀的生态宜居绿城。有国家级和省级自然保护区8个、森林公园15个,森林覆盖率40.5%,是千里淮河源头、南水北调中线工程渠首所在地和核心水源区,是全国重要的粮、油生产基地,素有“中原粮仓”之称。
南阳是一座活力进发的创新创业新城。同140多个国家和地区建立了经贸交流关系,卧龙综保区是全省第二家综保区,被确定为国家跨境电商综合试验区和零售进口试点城市,是国家创新型城市,中部地区发展最快,最具活力的城市之一。社会消费品零售总额稳居河南省第三位,常住人口城镇化率超过50%,正处于城镇化加速发展阶段,消费市场、城市建设潜力大、前景广。
南阳还是全国重要的新兴枢纽要地。焦枝、宁西铁路“十”字交汇,郑万高铁开通运行,南阳机场是全省四大机场之一,高速公路通车里程全省第一,成功开行“宛西欧”和RCEP班列,唐河航运开工建设,白河航运启动规划,被确定为全国性综合交通枢纽城市、商贸服务型国家物流枢纽城市。
2021年以来,乘着习近平总书记亲临考察的东风,借势河南省委赋予南阳建设省域副中心城市的定位,南阳加快推动制造业高质量发展,聚焦主导产业,链群集聚正在起势。希望重点在装备制造、绿色食品、光电信息、生物产业、新能源、冶金建材、油碱化工、纺织服装、新材料等领域深化合作。
真诚欢迎海内外朋友莅宛观光旅游、投资兴业,增进交流合作,扩大贸易往来,共享发展机遇,共创美好未来。
 产业发展情况
产业发展情况牢固树立“兴工强市”“工业立市”的发展战略
产业高度决定城市高度。在推进副中心城市建设过程中,我们牢固树立“兴工强市”“工业立市”的发展战略,以发展先进制造业为主攻方向,结合南阳实际,权流理确定了实施“5+N”千百亿产业集群培育计划、强力推进制造业发展“553”工程、集中打造21个重点产业链的发展思路。
制造业发展“553”工程:“十四五”末,力争打造绿色食品、装备制造、光电信息产业、生物制造产业、新能源5个千亿级产业集群;“十四五”末,力争打造冶金建材、油碱化工、纺织服装、新材料等300亿~500亿级产业集群;“3”即抓好牧原集团、中光学集团、淅减公司超前布局未来产业三件事。
集中打造21个重点产业链:即聚焦防爆电机、汽车及零部件、输变电装备、轴承、肉食品加工、农牧装备、粮油加工、食用菌、特种钢、绿色冶铸、碳酸钙微粉、碱化工、纺织服装、数字光电、传感器、5G、生物与新医药、中药制品、超硬材料、玉产品、印刷包装新材料21个重点产业链,落实产业链链长、产业联盟会长、行业协会秘书长“三长制”,强力实施补链延链强链行动,一链一策、梯度培育,力争到“十四五”末,21个产业链主营业务收入达到5000亿元以上。
 实施“5+N”千百亿产业集群培育计划
实施“5+N”千百亿产业集群培育计划实施“5+N”千百亿产业集群培育计划,即到“十四五”末,力争培育形成5个千亿级和N个百亿级产业集群。
一是依托光学元组件、智能传感器、电子元器件等重点产业,打造千亿级电子信息产业集群;
二是依托现代中医药、化学制药、动物保健等重点产业,打造千亿级生物产业集群;
三是依托防爆电机、汽车及零部件、输变电装备等重点产业,打造千亿级装备制造业产业集群;
四是依托肉食品加工、面制品加工、食用油脂等重点产业,打造千亿级绿色食品产业集群;
五是依托南阳得天独厚的天然山石资源、富集的人力资源优势,打造千亿级文旅康养产业。
 电驱防爆产业
电驱防爆产业电驱防爆产业是南阳传统优势产业,在防爆电机生产制造及研发领域占据龙头地位。
全市电驱(防爆)产业链现有企业200多家,从业人员2.1万人,2022年上半年实现销售收入56.2亿元。其中,产业上游企业186家,中游企业26家,下游企业15家,产品主要应用于石油、煤矿、化工、冶金、电力、军工、核电等领域。

 链主企业:卧龙电气南阳防爆集团
链主企业:卧龙电气南阳防爆集团汽车零部件产业
南阳汽车零部件产业集群化效应已经初现,区域竞争优势逐步形成,并经省政府批准成立了汽车及零部件产业出口基地。
汽车工业企业131家,其中,汽车零部件企业108家,专用车生产企业18家,新能源汽车零部件企业5家。

 链主企业:南阳淅减汽车减振器有限公司
链主企业:南阳淅减汽车减振器有限公司中医药产业
南阳是“医圣”故里,拥有得天独厚的中药资源优势、文化优势,中医药产业基础雄厚。
中药材种植面积185万亩,全市中药材种植年产值60亿元。
拥有规上中药企业55家,龙头企业8家,上市企业1家,新三板挂牌企业3家,药品生产质量管理规范(GMP)认证的中药制药企业31家。

 链主企业:河南省仲景宛西制药股份有限公司
链主企业:河南省仲景宛西制药股份有限公司输变电装备产业
南阳输变电装备产业集群效应初步形成,产品应用广泛、消费市场潜力较大,正迎来前所未有的发展机遇。相关企业32家,其中规上企业16家。
初步形成了以河南天力电气为龙头的变压器生产制造企业、以南阳金冠电气为龙头的避雷器及输配电控制设备研发制造企业,汇集了鑫特电气有限公司、中祥电力电子股份有限公司等具有一定区域影响力的骨干企业。

 链主企业:河南天力电气科技有限公司
链主企业:河南天力电气科技有限公司肉食品加工产业
南阳是畜牧业大市,畜禽饲养量位居全省前列,拥有26家规上生产加工企业。肉食品加工产业链涵盖生猪、肉牛、肉羊、肉(蛋)鸡、奶业,主要涉及26家规上生产加工企业和配套企业。今年上半年,全市生猪、肉牛、羊、家禽预计出栏量分别达到530万头、28万头、200万只、2500万只,肉蛋奶预计总产量75万吨,各项指标均比上年同期稳步增加;26家产业链群企业实现营业收入85.44亿元,同比增长32.76%。
 链主企业:牧原股份有限公司
链主企业:牧原股份有限公司生物产业
南阳生物产业为河南首批15个省级战略性新兴产业集群之一,其核心生物医药产业已呈集聚发展态势。
链主企业:南阳启泰制药有限公司
链主企业:南阳启泰制药有限公司数字光电产业
南阳是全国三大光学冷加工基地之一,光电产业呈快速发展、集聚效应凸显,竞争力不断增强的趋势。产销各类镜片(棱镜、透镜、特种元件等)3亿片、光学镜头300万只、功能镀膜产品5000万片、光学引擎100万台、投影机45万台。全市光电制造企业200余家,其中规模以上光电企业50余家,骨干企业有中光学集团股份公司、森霸传感科技、凯鑫光电,翊轩光电、旭润光电、格瑞光电、镀邦光电等。

 链主企业:中光学集团股份有限公司
链主企业:中光学集团股份有限公司超硬材料产业
南阳已形成超硬材料闭合产业链条,拥有产业链企业27家,其中龙头骨干企业8家。全市共有超硬材料产业链企业26家,年产值35亿元,从业人员5000余人。产品主要有压力铰链梁、六面顶压机、合金顶锤、金属触媒粉、人造金刚石、宝石级大颗粒钻石、金刚石微粉、金刚石刀具磨具等5大类别1000余个品种。龙头骨干企业8家,分别是:中南钻石有限公司、神州灵山新材料有限公司、永泰磨具有限公司、中钻新材料有限公司、中硬合金有限公司、潭龙新料有限公司、中线新材料有限公司、中晶钻石有限公司。

 链主企业:中南钻石有限公司
链主企业:中南钻石有限公司纺织服装产业
南阳是河南省纺织工业大市,产业基础雄厚。登记注册纺织及服装企业1974家,其中规模以上纺织及服装企业128家。年产纱56.78万吨,年产布36547.78万米,年产服装2501.30万件。

 链主企业:河南新野纺织股份有限公司
链主企业:河南新野纺织股份有限公司农牧装备产业
南阳市共有农牧装备产业链企业54家,主要产品涵盖智慧化养猪设备、智能巡检机器、畜牧净化设备,以及旋耕机、播种机、收割机等,形成了以寅兴农牧、南商农科、牧原智能科技、亚澳农机等为龙头,以恒辉农牧、和信农牧、大华机械为重点的产业链条。

 链主企业:河南寅兴牧业设备有限公司
链主企业:河南寅兴牧业设备有限公司碱化工产业
碱化工产业是南阳市“龙腾计划”九大特色产业链条之一(油碱化工),目前纯碱年产能180万吨,小苏打年产能130万吨。天然碱储量1.8亿吨,居亚洲第一。

 链主企业:河南中源化学股份有限公司
链主企业:河南中源化学股份有限公司轴承产业
南阳轴承产业已经形成了以勤大钢管和瀚瑞特轴承为龙头的轴承产业集群,主要集中在上游零部件领域以及中游轴承制造领域。南阳轴承产业主要集中在方城县。目前方城县产业集聚区入驻轴承及相关联企业65家,其中轴承制造重点企业28家,规上企业17家,年销售收入25亿元。

 链主企业:河南瀚瑞特轴承有限公司
链主企业:河南瀚瑞特轴承有限公司传感器产业
南阳市传感器产业处于起步期,主要有森霸传感科技股份有限公司、南阳市华业防爆仪表有限公司等企业,产品类型集中在热释电红外、光敏电阻、防爆仪表等领域。
规上企业2家,森霸传感科技股份有限公司和南阳市华业防爆仪表有限公司。

 链主企业:森霸传感科技股份有限公司
链主企业:森霸传感科技股份有限公司特钢产业
南阳是国内最大的冶金保护材料生产基地、省级冶金保护材料出口基地和全国特厚钢产业基地之一。
特钢产业链企业300余家,亿元以上企业18家,其中:产值超百亿企业2家(龙成集团、西保集团);超10亿元企业2家(龙成特材、通宇)。

 链主企业:河南成龙集团有限公司
链主企业:河南成龙集团有限公司印刷包装新材料产业
南阳市印刷包装新材料产业以氧化硅高阻隔膜为核心,以基础薄膜、高阻隔膜、软包装、智能包装为重点,服务于南阳当地整体产业发展。产业链相关企业10家,其中链主企业2家,配套企业3家。产业链相关企业年产值近100亿。

 链主企业
链主企业粮油加工产业
南阳市现有规模以上粮油加工企业79家。
重点粮油加工企业有想念食品、牧原食品等企业,初步形成了以各类面粉、大米、食用植物油等成品。

 链主企业:想念食品有限公司
链主企业:想念食品有限公司绿色冶铸产业
南阳绿色冶铸产业总体呈现规模小而分散的局面,存在缺乏铸造龙头企业,没有形成合力,各自发展,产业发展结构不均衡,缺乏产业集群效应等问题。产业链相关企业10家,其中龙头企业1家。

 链主企业:天瑞集团云阳铸造有限公司
链主企业:天瑞集团云阳铸造有限公司碳酸钙微粉产业
南阳市南召县重质碳酸钙方解石资源丰富,量大质优,碳酸钙产业是南召县最具发展潜力的朝阳产业之一,多年来为县域经济发展做出了重大贡献。现南阳市有矿山企业2家,粉体加工企业241家,下游产品加工企业9家。

 链主企业:河南鑫泰钙业有限公司
链主企业:河南鑫泰钙业有限公司食用菌产业
南阳已形成以西峡为主集生产、加工、销售为一体的完整香菇产业链,成为全国最大的香菇标准化生产基地、全国最大的香菇交易市场、全国最大的生产、加工、出口基地。已建立食用菌专业合作社371家以上,加工企业300多家以上,其中出口企业142家,规模以上企业56家以上。

 链主企业:仲景食品股份有限公司
链主企业:仲景食品股份有限公司5G产业
南阳市5G产业已建设完成5G基站7115个,实现乡镇以上区域5G网络连续覆盖,5G终端用户数300万户,全市5G产业规模近30亿元。5G重点企业11家,智能终端配套企业7家,5G应用企业有4家,全市5G产业规模30亿,在建项目5个,投资额18.06亿,新谋划项目5个,总投资额1.12亿元。

 链主企业:河南镀邦光电股份有限公司
链主企业:河南镀邦光电股份有限公司玉文化产业
南阳从事玉雕加工行政村100多个,玉雕专业村50个。
玉雕专业户近1.5万户,大型玉雕专业市场10个,玉雕精品门店、摊位3万多个,从业人员达30万人。

 链主企业:镇平县中安产业开发有限公司
链主企业:镇平县中安产业开发有限公司营商环境
南阳牢牢坚持“项目为王”的发展理念,滚动实施签约一批、开工一批、达产一批“三个一批”活动,探索建立“周例会、月签约、季集中开工、半年观摩、年终考评”等工作制厂度,全面推广“一天办四证”“拿地即开工”等模式和容缺办理、多规合一、区域评估等机制,全生命周期、高效闭环推动重大项目谋划建设,有力有效地支撑了经济社会的持续健康发展。
为将南阳打造成全国最具活力的投资兴业之城,我们旗帜鲜明提出“像尊重科学家一样尊重企业家,像尊敬老师一样尊敬老总”的口号,将每年5月18日确定为“南阳市企业家节”,每月16日确定为“企业服务日”,每月28日举办项目签约和建设推进日活动,集中签约项目,通报落后县市区、单位,传导压力、鞭策激励。持续深化“放管服效”改革,强力开展“万人助万企活动”,争当企业的“金牌店小二”全力营造审批最少、流程最优、体制最顺、机制最活、效率最高、服务最好的“六最”营商环境,做到不叫不到、随叫随到、热情周到,在全社会凝聚形成了助企、安企、兴企、强企的发展共识和浓厚氛围,也因此成为过去两年全省营商环境改善最大、进步最快的地市。
实现“一天办四证”“拿地即开工”,优先保障重大项目用地需求,水电气暖“一件事”办理。改进工作作风,优化营商环境,做到一网通办,只进一扇门,最多跑一次。
南阳市加强招商引资十四条措施
为深入贯彻落实省第十一次党代会、市第七次党代会的决策部署,着力谋开放、抓招商、扩投资,为打造河南省副中心城市助力赋能,结合我市实际,制定以下措施。
一、聚焦主导产业招商
(一)明晰产业招商方向。坚定不移把产业招商作为重中之重,围绕培育打造“5+N”千百亿产业集群,鼓励支持各县(市、区)聚焦主导产业抓招商,积极招引先进制造业、战略性新兴产业等项目。优先鼓励支持外商投资先进制造业、战略性新兴产业、未来产业、生产性服务业。(责任单位:市招商投资促进局、发展改革委、工业和信息化局,各县〔市、区〕人民政府〔管委会〕)
(二)明确产业招商目标。市直部门按照管行业必须抓招商的原则承担量化招商任务。各县(市、区)党政主要负责同志实行二分之一工作法,“十四五”期间,各县(市、区)每年至少新招引落地一个10亿元以上或两个5亿元以上先进制造业项目,力争新招引落地一个30亿元以上先进制造业项目。(责任单位:市招商投资促进局、发展改革委、工业和信息化局、科技局、民政局、财政局、人力资源和社会保障局、自然资源和规划局、生态环境局、住房和城乡建设局、水利局、交通运输局、农业农村局、文化广电和旅游局、卫生健康体育委员会、中医药发展局、商务局、教育局、金融工作局、政务服务和大数据管理局、乡村振兴局、林业局、粮食和物资储备局、市场监督管理局、城市管理局、卧龙综合保税区、京(津)宛合作中心、市投资集团、市产投集团、市交投集团,各县〔市、区〕人民政府〔管委会〕)
二、强化招商激励举措
(三)设立市级招商引资专项资金。依据《河南省人民政府关于加强新形势下招商引资工作的意见》(豫政〔2020〕22号)、《河南省省级招商引资专项资金管理办法》(豫财贸〔2018〕62号)、《南阳市人民政府关于进一步扩大对外开放若干措施的通知》(宛政〔2020〕5号),设立市级招商引资专项资金,纳入市财政年度预算,统筹用于扶持奖励重大招商引资项目、加强投资促进活动、鼓励社会化专业化招商等。市级招商引资专项资金管理办法由市财政局会同市招商投资促进局另行制定。鼓励各县(市、区)设立招商引资专项资金。(责任单位:市财政局、招商投资促进局,各县〔市、区〕人民政府〔管委会〕)
(四)实行战略性新兴产业项目奖励。对本政策生效后在我市落地的战略性新兴产业项目,纳入规模以上工业企业名录库后,年产值首次突破0.5亿元、1亿元、3亿元、5亿元、10亿元以上(本政策中所指“以上”均含本数)的,分别给予10万元、20万元、50万元、100万元、300万元的一次性奖励。(责任单位:市招商投资促进局、财政局、发展改革委、工业和信息化局、科技局、统计局,各县〔市、区〕人民政府〔管委会〕)
(五)实行主导产业项目奖励。对符合我市“5+N”千百亿产业集群培育计划发展方向、固定资产一次性投资在1亿元以上的项目,投产运营后,第1—3年按年地方财政贡献的100%予以奖励,第4—5年按年地方财政贡献的50%予以奖励,累计奖励不高于项目的实际固定资产投资额。对在我市设立总部、区域总部及研发中心、技术中心、采购中心、结算中心等功能性机构的企业,第1—2年按企业年地方财政贡献的100%给予奖励,第3—5年按企业年地方财政贡献的50%给予奖励,奖励资金用于支持企业科研创新、扩大投资、开拓市场等。对世界500强、中国500强、中国民营500强、央企、行业龙头企业等在我市设立总部的,实行“一事一议”。(责任单位:市招商投资促进局、财政局、税务局、发展改革委,各县〔市、区〕人民政府〔管委会〕)
(六)实行招商中介奖励。对成功引进符合我市“5+N”千百亿产业集群培育计划发展方向的市外优质项目(非财政直接投资)的各类商协会、中介机构和非国家公职人员(统称招商引资中介),内资项目投资额1亿元以上,按照项目投产运营之日完成固定资产投资额的4‰给予一次性奖励,最高不超过200万元;新设外资项目注册资本金中合同外资在500万美元以上的,按照实际到位外资企业注册资本金等值人民币的5‰给予奖励(对实际到位资金为外币的,按照实际到位当日中国银行公布的人民币汇率基准价折算。下同),最高不超过300万元,项目资本金分批注入的可累计计算不超过2年。同一个项目只认定一个招商引资中介。对重大委托招商项目,可根据产业导入情况和绩效考核结果,采取“一事一议”的办法给予奖励。(责任单位:市招商投资促进局、财政局,各县〔市、区〕人民政府〔管委会〕)
(七)实行利用外资奖励。对落地我市的境外资金项目,每实际到位外资企业注册资本金100万美元(或等值人民币),奖励5万元人民币,最高奖励不超过100万元人民币。对落地我市的世界500强投资的外资项目,按实际到位外资企业注册资本金等值人民币的5%予以奖励,最高奖励不超过100万元人民币。鼓励外商采用并购方式参与我市主导产业、传统产业的重组与改造,按照并购后实际到位外资企业注册资本金等值人民币的1.5%予以奖励,最高奖励不超过100万元人民币。项目资本金分批注入的可累计计算不超过2年。特别重大外资项目,采取“一事一议”予以支持。(责任单位:市招商投资促进局、财政局、发展改革委,各县〔市、区〕人民政府〔管委会〕)
(八)实行产业链以商招商奖励。鼓励市内产业集群龙头、骨干企业牵头引进集群配套、强链延链补链项目,对引进符合我市“5+N”千百亿产业集群培育计划发展方向的重点项目,分别给予项目实施主体和牵头引进企业(指市内引进市外项目的招商企业)奖励。其中,项目投产运营之日完成固定资产投资额在5亿元(含5亿元)—20亿元,分别奖励100万元;20亿元(含20亿元)—50亿元,分别奖励200万元;50亿元以上的,分别奖励300万元。项目投产后,先兑现30%奖励资金,项目达产后,再兑现70%奖励资金。(责任单位:市招商投资促进局、财政局、工业和信息化局、发展改革委,各县〔市、区〕人民政府〔管委会〕)
三、健全要素保障体系
(九)加强土地要素保障。推行工业“标准地”出让,实行“标准地+代办制+告知承诺制”出让模式,最大限度压缩企业开工时间,实现“一天办四证”“拿地即开工”。对招引的先进制造业、战略性新兴产业等工业项目和重大外资项目,按照相关规定,通过用地奖补,使获得土地成本在同类项目中全省最低。支持和鼓励各县(市、区)建设高标准厂房和工业大厦,2层以上且带工业电梯的高标准厂房和工业大厦,可按幢、层等为基本单元进行不动产首次登记。(责任单位:市自然资源和规划局、住房和城乡建设局、财政局、市不动产登记服务中心,各县〔市、区〕人民政府〔管委会〕)
(十)加强金融和产业资本支持。完善金融部门与招商部门的对接机制,在项目洽谈对接阶段,金融部门组织相关金融机构全程参与;项目签约后,招商部门及时将签约项目信息推送给金融部门,由金融部门组织相关金融机构为签约项目提供优质金融服务。对纳入省、市确定的重大招商引资项目,可联合省、市、县级引导基金与社会资本合作,量身定制项目基金。鼓励各县(市、区)联合社会资本设立产业投资基金,支持重大招商引资项目建设。(责任单位:市金融工作局、财政局、发展改革委、招商投资促进局,各县〔市、区〕人民政府〔管委会〕)
四、完善招商工作机制
(十一)落实“飞地经济”利益共享机制。创新开发区合作机制,鼓励“飞地经济”发展,“飞入地”与“飞出地”项目实施财税分成、利益共享。利益分享期原则上为10年。对新上产业项目,自投产形成税收后10年内缴纳的增值税、企业所得税县级留成部分,“飞出地”与“飞入地”原则上按5:5比例分享;对既有企业搬迁项目,自投产形成税收后10年内缴纳的增值税、企业所得税县级留成部分,前5年“飞出地”与“飞入地”原则上按6:4比例分享,后5年按4:6比例分享。以“股份合作”模式开展合作的,收益按照双方股本比例分成。重大项目双方可协商确定分享比例。税收由“飞地经济”园区所在地税务机关负责征收,按属地原则缴库。“飞地经济”园区相关统计指标实行所在地统计,由“飞入地”政府统计部门负责统计;考核时按分享比例以标注形式计入“飞出地”,同时对“飞入地”进行相应扣除。非“飞地经济”合作开发区(园区)单个招商项目的飞入飞出,参照“飞地经济”利益分成执行。(责任单位:市发展改革委、财政局、税务局、统计局,各县〔市、区〕人民政府〔管委会〕)
(十二)实施产业链链长负责制。对重点产业实施产业链链长负责制,即每个产业明确一名市厅级领导任链长,一个产业主管部门为牵头单位,一个链主企业,一个提升方案,一个推进专班,统筹负责整个产业链的规划、招商、运营服务和要素保障等。(责任单位:市工业和信息化局、市直有关部门,各县〔市、区〕人民政府〔管委会〕)
(十三)实施招商引资考评奖惩机制。实行周动态发布、月排名通报、季综合考评、年终总评,根据考评结果,给予县(市、区)、驻外招商合作发展中心、承担招商引资任务的市直部门激励与处罚。(责任单位:市招商投资促进局、人力资源和社会保障局、市委市政府督查局,各县〔市、区〕人民政府〔管委会〕)
五、附则
(十四)签约项目没有明确开工和建成期限的,不享受本政策优惠;未按合同约定期限开工和建设投产的,相应缩短享受本优惠政策期限;项目分期实施的,首期建成投产一般不超过2年,两期不超过4年,整体不超过5年。兑现本政策需要的资金,落户在县(市)的项目由各县(市)财政承担,落户在中心城区(功能区)的项目由市、区(功能区)财政按照税收收益比例承担。符合本政策的项目单位每年向隶属县(市、区)招商(商务)部门申报,县(市、区)招商(商务)部门会同同级财政部门组织有关专家对项目进行评审,按照规定进行公示和资金拨付等。需拨付市级资金的,由区政府(管委会)审核后报市招商、财政部门,经审定后由市财政部门下达相应资金到区财政部门,由区财政部门予以拨付。同一项目符合本政策中多项奖励的,按照就高不就低的原则,只享受本政策中的一项奖励,不得重复申报。享受“一事一议”政策的企业和其他经营主体项目,不享受本政策体系内的其他奖励。本地原有企业新上项目与新引进项目同等享受本政策。
本政策自印发之日起施行。我市原有政策与本政策规定不一致的,按照“就高不就低”的原则执行。
需求清单




 中国侨商投资(河南)大会即将启幕
中国侨商投资(河南)大会即将启幕为搭建广大侨商与河南合作交流平台,展示河南开放合作新形象,中国侨联、河南省人民政府将于11月27日-30日在郑州举办“中国侨商投资 (河南) 大会”。
此次大会坚持招商引资与招才引智并举、投资贸易并重,以专题推介、产业对接、项目洽谈、实地考察等为主要内容,旨在搭建河南省与知名侨商合作交流高端平台,汇聚侨资侨力侨智,打好新时代“侨”牌,更大力度吸引广大侨商来豫投资兴业,为在新征程上奋力推进中国式现代化建设河南实践提供侨界支撑。
原标题:《中国侨商投资(河南)大会系列宣传——南阳》
本文为澎湃号作者或机构在澎湃新闻上传并发布,仅代表该作者或机构观点,不代表澎湃新闻的观点或立场,澎湃新闻仅提供信息发布平台。申请澎湃号请用电脑访问http://renzheng.thepaper.cn。





- 报料热线: 021-962866
- 报料邮箱: news@thepaper.cn
互联网新闻信息服务许可证:31120170006
增值电信业务经营许可证:沪B2-2017116
© 2014-2026 上海东方报业有限公司




